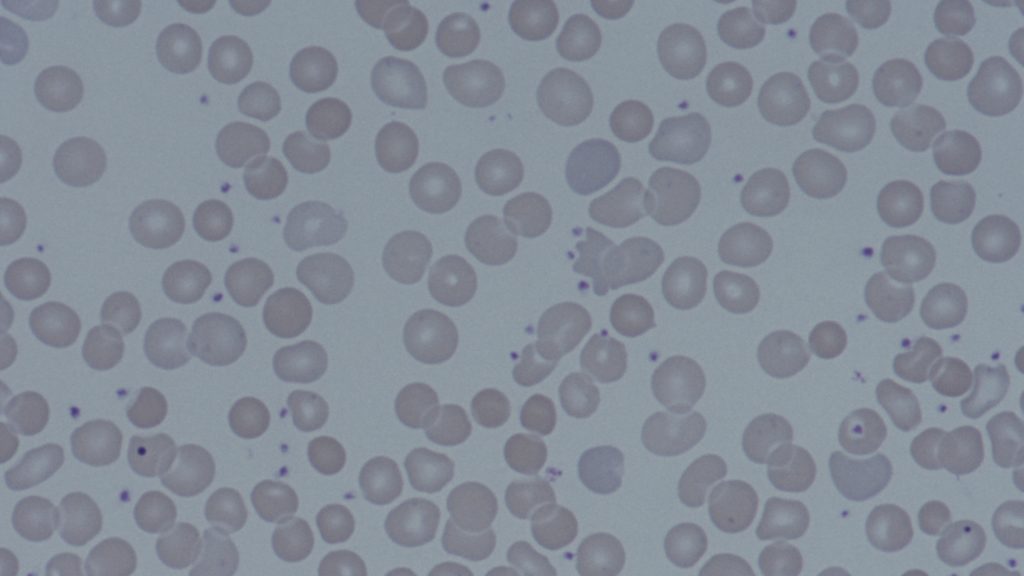

Dr Mark Bishton on Haemophagocytic Lymphohistiocytosis (HLH)
Fetal and neonatal alloimmune thrombocytopenia with Elina Vlachodimitropoulou and Mike Desborough

Suzy talks to Elina Vlachodimitropoulou, consultant obstetrician, and Mike Desborough, consultant haematologist, about FNAIT
CLL management with Dr Renata Walewska
Polycythemia with Dr Hayder Hussein
Suzy and Hayder discuss the investigation of patients with high haemotocrtis and delve into treatment aspects of primary and secondary polycythemia
Von Willebrand Disease – Dr Will Lester

The categorisation and management of the different types of Von Willebrand Disease can be confusing. Dr Will Lester explains how best to approach the diagnosis and how management differs depending on the subtype. Learning points Usual presentation is with mucocutaneous/’platelet type’ bleeding Bleeding assessment tool (BAT) is a research tool but can help with history […]
Vaccine Induced Thrombosis and Thrombocytopenia – Dr Will Lester

Helen talks to Dr Will Lester about Vaccine Induced Thrombosis and Thrombocytopenia
Thrombophilia – Dr Will Lester

Thrombophilia testing can be confusing. Dr Will Lester speaks to Helen about when it’s useful… and when it’s not
Special components in transfusion – Dr Suzy Morton

Helen talks to Suzy Morton about different blood components and when they are indicated. Links: NHSBT portfolio of blood components NHSBT guidelines on management of IgA deficiency Platelet refractoriness review (Stanworth et al. BJHaem 2015) BSH guidelines: indications for irradiated blood SaBTO CMV guidance 2012
Platelet aggregometry and inherited platelet disorders – Dr Gill Lowe

Familial ITP is very rare so if a FH exists, think about hereditary platelet disorders. Get historical plt counts and bleeding challenge history. Investigations: Conditions covered include storage pool disorders (alpha and dense), glycoprotein deficit disorders, MYH9 syndrome, TAR, Wiskott Aldrich. References: wiley.com
Patient blood management and iron deficiency – Dr Suzy Morton

Everyone talks about patient blood management but what actually is it? Helen quizzes Dr Suzy Morton on the practical elements of patient blood management, including a run through a practical approach to iron deficiency. Learning Points: Patient blood management is the multidisciplinary, evidence based approach to care of patients who may need a transfusion. Practically […]